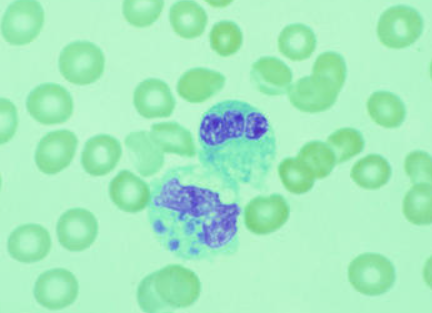

1.查菲埃立克体(Ehrlichia chaffeensis)
物种名:查菲埃立克体
拉丁学名:Ehrlichia chaffeensis
分类学地位:细菌界Bacteria;变形菌门Proteobacteria;
α-变形菌纲Alpha-proteobacteria;立克次体目Rickettsiales;
无形体科Anaplasmataceae;埃立克体属Ehrlichia
查菲埃立克体(Ehrlichia chaffeensis)会通过蜱虫传染,感染人类会攻击白细胞(主要是单核细胞和巨噬细胞),导致患人单核细胞埃立克体病(HME),该病属于轻中度急性传染病,感染后可能出现发热、头晕、恶心、呕吐、全身酸痛等类似感冒症状,除此之外还可能出现咳嗽、咽炎、淋巴结肿大、腹泻、呕吐、腹痛和精神状态改变等。
1.1生物学特性
1.1.1培养特征
查菲埃立克体为严格细胞内寄生菌,常用的培养细胞有犬组织细胞瘤系DH82细胞、人肺成纤维细胞(HEL)、鼠胚胎细胞等。查菲埃立克体在DH82细胞中培养,可见细胞边缘具有突出的褶皱外细胞膜(图1)。在人抗凝全血中,可以存活11天。4-6℃条件下,在细胞培养基中可存活21天[1]。

图1 查菲埃立克体在DH82细胞中培养特征[1]
1.1.2形态学特征
查菲埃立克体在光学显微镜下主要以包涵体的形式存在于宿主细胞胞质内的空泡中,形似桑甚,也称为桑葚体,用吉姆萨染色,可见查菲埃立克体包涵体被染成紫色(图2)。而电子显微镜下,存在球形及球杆形2种形态。球形体是中心电子密度增高的类核DNA和核糖体,又叫实体,大小为(0.4-0.6) μm;球杆形体核糖体及类核DNA纤维均匀一致地分布于整个细胞质,又叫网状体,大小为(0.4-0.6) μm×(0.7-1.9) μm。这两种类型的细胞均以二分裂方式繁殖,均具有革兰氏阴性菌细胞壁,含有极丰富的肽聚糖[1]。
图2 查菲埃立克体光学显微镜下照片[1]
1.1.3分子生物学特征
查菲埃立克体有7种主要蛋白抗原,分子质量分别为120 ku、66 ku、55 ku、44 ku、29 ku、28 ku和22 ku。查非埃立克体有一个28 ku抗原蛋白家族,由多个23-31 ku的同源蛋白所组成,至少有17个基因编码这些分子质量不同的同源蛋白[2]。
1.2分布、传播与致病性
1.2.1分布与传播
人单核细胞埃立克体病在世界各地区均有发现,目前在美国、欧洲及非洲较为流行,在我国云南、内蒙古等地也有发现。查菲埃立克体可存在于自然环境中,如土壤、水等,该菌主要通过感染蜱虫而寄生于其体内,再通过蜱虫叮咬而导致人类患病。因此,每年的春季4-6月是蜱虫的活跃期,也是埃立克体病的高发期[3]。
1.2.2致病性
蜱传埃立克体是通过蜱的叮咬进入人体内,通过血管和淋巴管传播,攻击白细胞、造血和网状内皮系统细胞,主要是单核细胞和巨噬细胞。血管周围淋巴细胞浸润出现在肝脏、脾脏和许多其他器官,包括肾脏、心脏、脑膜和肺。受感染细胞的分解导致微生物释放到血液中,并导致感染的继发性传播。查菲埃立克体感染与强烈的发热反应和免疫抑制有关,白细胞数量减少和血小板减少症是查菲埃立克体感染的典型症状[4]。
查菲埃立克体通过细菌效应蛋白(TRP120、透明质酸酶、EtpE等)与细胞表面受体相互作用的方式粘附和入侵宿主细胞。寄生在胞质空泡中,以膜包裹的包涵体形式生存和繁殖。该菌的致病机制主要有以下几类[5]:(1)查菲埃立克体缺乏编码肽聚糖和脂多糖生物合成的基因,因此无肽聚糖和脂多糖可与单核巨噬细胞产生的模式识别受体结合,从而不能有效激活宿主的天然免疫应答。(2)查菲埃立克体感染会导致机体中单核细胞的粒细胞和吞噬细胞克隆刺激因子以及α-肿瘤坏死因子的表达受到抑制。这些细胞因子的缺少可以延迟机体的抗埃立克体免疫的产生,而有利于埃立克体在吞细胞内的繁殖。(3)埃立克体感染导致宿主细胞裂解和组织损伤埃立克体在吞噬细胞内生长繁殖,可直接引起细胞的裂解;另外,埃立克体感染诱发机体的免疫应答,产生的抗埃立克体的抗体可与宿主细胞表面的埃立克体抗原结合,介导免疫活性细胞对宿主细胞的攻击。
1.3检测方法
(1)传统方法:去可以样本进行涂片后进行吉姆萨染色,在光学显微镜下观察,可见单核细胞的胞质内有呈圆形的包涵体,并且该包涵体被染成紫色。
- 分子生物学方法:目前查菲埃立克体分子检测常用的靶基因主要包括16S rRNA以及编码热休克蛋白groEL、P28蛋白、GP120蛋白、变异性长度PCR靶序列。其中16S rRNA高度保守,是PCR检测最常用扩增靶基因,引物序列如下[6]:
表1 查菲埃立克体q-PCR引物序列
| 名称 | 序列 |
| ECH16S-17 | 5′-GCGGCAAGCCTAACACATG-3′ |
| ECH16S-97 | 5′-CCCGTCTCCCACTAACAATTATT-3′ |
| 探针ECH16S-38 | 5′-AGTCGAACGGACAATTCCTTATAACCTTTTGGT-3′ |
1.4典型案例
2010年9月上旬,山东省疾病预防控制中心接到蓬莱市报告的4例可疑人粒细胞无形体病病例标本,经流行病学调查和实验室检查,确认该4例病例为山东省2010年疫情网络直报的首起嗜吞噬细胞无形体和查菲埃立克体符合感染病例[7]。
1.5防治对策
控制媒介与宿主动物,出现疫情,灭蜱、鼠和进行环境清理。对污染物、排泄物应及时消毒处理。春夏季节在蜱生长繁殖活跃地区的人员以及前往蜱媒传播传染病疫区的旅游者尤其需要注意防护,尽量减少皮肤暴露在环境中的时间。治疗可采用四环素类,如多西霉素等。
参考文献
[1] Paddock CD, Childs JE. Ehrlichia chaffeensis: a prototypical emerging pathogen. Clin Microbiol Rev, 2003, 16: 37-64.
[2] 文心田, 于恩庶, 徐建国 等. 当代世界人兽共患病学. 成都: 四川科学技术出版社, 2011.
[3] 张文丽, 陈志海. 我国人单核细胞埃立克体病流行特点及其防治. 中华流行病学杂志, 2014, 35: 970-973.
[4] Parija SC. Textbook of microbiology and immunology. Springer: India, 2023.
[5] 程琰, 于学杰, 王缚鲲. 查菲埃立克体致病机制研究进展. 中国人兽共患病学报, 2019, 35: 738-743.
[6] 彭芸, 赵桂萍, 宝福凯 等. 查菲埃立克体分子检测技术研究进展. 临床检验杂志, 2016, 34: 846-849.
[7] 王爽, 寇增强, 王梅 等. 一起人粒细胞无形体和查菲埃立克体符合感染病例的确认和调查. 疾病监测, 2012, 27: 642-643.
.png)
